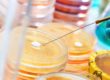
How To Select Vacuum Dryer
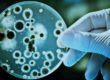
Related-Equipment-For-Cell-Culture-1

When cultivating certain anaerobic organisms, ordinary ordinary incubators will cause the organisms to die because they contain oxygen. Therefore, the anaerobic incubator can meet the growth needs of anaerobic organisms, and can effectively avoid the risk of death of anaerobic organisms due to exposure to oxygen.
The working principle of anaerobic incubator: Anaerobic incubator, also called anaerobic workstation, is a device for culturing and operating bacteria under anaerobic conditions. This device can provide strict anaerobic conditions, constant culture temperature, and a systematic work area.
Structural composition of anaerobic workstation:
- Anaerobic chamber: The inner cavity achieves constant temperature, humidity control, deaeration, and sterilization. The operation room and the cultivation room are performed in a common space.
- Transmission cabin: With a compact tube design, one person, one hand can easily transfer samples.
- Operation hole: Put the latex gloves on the operation hole, hands can be put on the latex gloves, freely manipulate the samples in the studio
- Control system: Real-time status display and alarm function to ensure the normal operation of the equipment.
Operation method of anaerobic workstation
- Form an anaerobic environment
- Place all utensils according to the needs of the experiment.
- Power on, turn on the light, turn on the temperature controller, and adjust the required temperature.
- Put palladium particles, oxygen scavenger and desiccant into the operation room.
- Close the door inside and outside the sampling chamber and evacuate
- First replacement of operating room (nitrogen replacement):
a. Connect the nitrogen gas path and open the nitrogen control valve to make the gloves bulge. After the two plastic bags bulge, tighten the mouth of the bag.
b. Put the latex gloves on the flange ring and fasten them, then exhaust the nitrogen in the plastic bag and put them into the operation room.
- Second replacement of operating room (nitrogen replacement)
- The third replacement of the operating room (mixed gas replacement), the proportion of mixed gas is N2 85% H2 10% CO25%
- Turn on the power of the deaeration catalyst for catalytic deaeration.
- Turn on the ultraviolet sterilization lamp for sterilization.
2.Insertion and cultivation of bacteria
- Check the door of the sampling chamber and close it tightly.
- Open the door outside the sampling room, put the bacteria in the sampling room, and close the outside door.
- The sampling chamber was replaced with nitrogen three times.
- Open the door of the sampling chamber, move the bacteria into the operating room, and close the inner door tightly. Vacuum to check if the inner door is closed tightly.
- Adjust the temperature of the operating room.
- Output pressure adjustment of mixed gas cylinder and nitrogen cylinder. Adjust the pressure reducing valve, the output pressure is 0.1MPa.
Trade crypto, Forex, CFDs, and stocks with confidence today Cancapital Union Trading
Notes on anaerobic incubator
- Observe the instruction sheet in the operating room every day.
- Continuously input a small amount of mixed gas for a long time to ensure the anaerobic state. The flow rate of the mixed gas to be replenished is 10ML per minute.
- Continuous culture operation for one day, change the oxygen scavenger and desiccant once
- The culture must be placed after the operating room has reached absolute anaerobic conditions.
- Regularly check for air leaks in the air circuit
- When replacing the cylinder, pay attention to tighten the air pipe to avoid inflow of oxygen-containing gas.
- In the event of a malfunction, the operating room can remain anaerobic for several hours.
- Check the vacuum pump regularly.